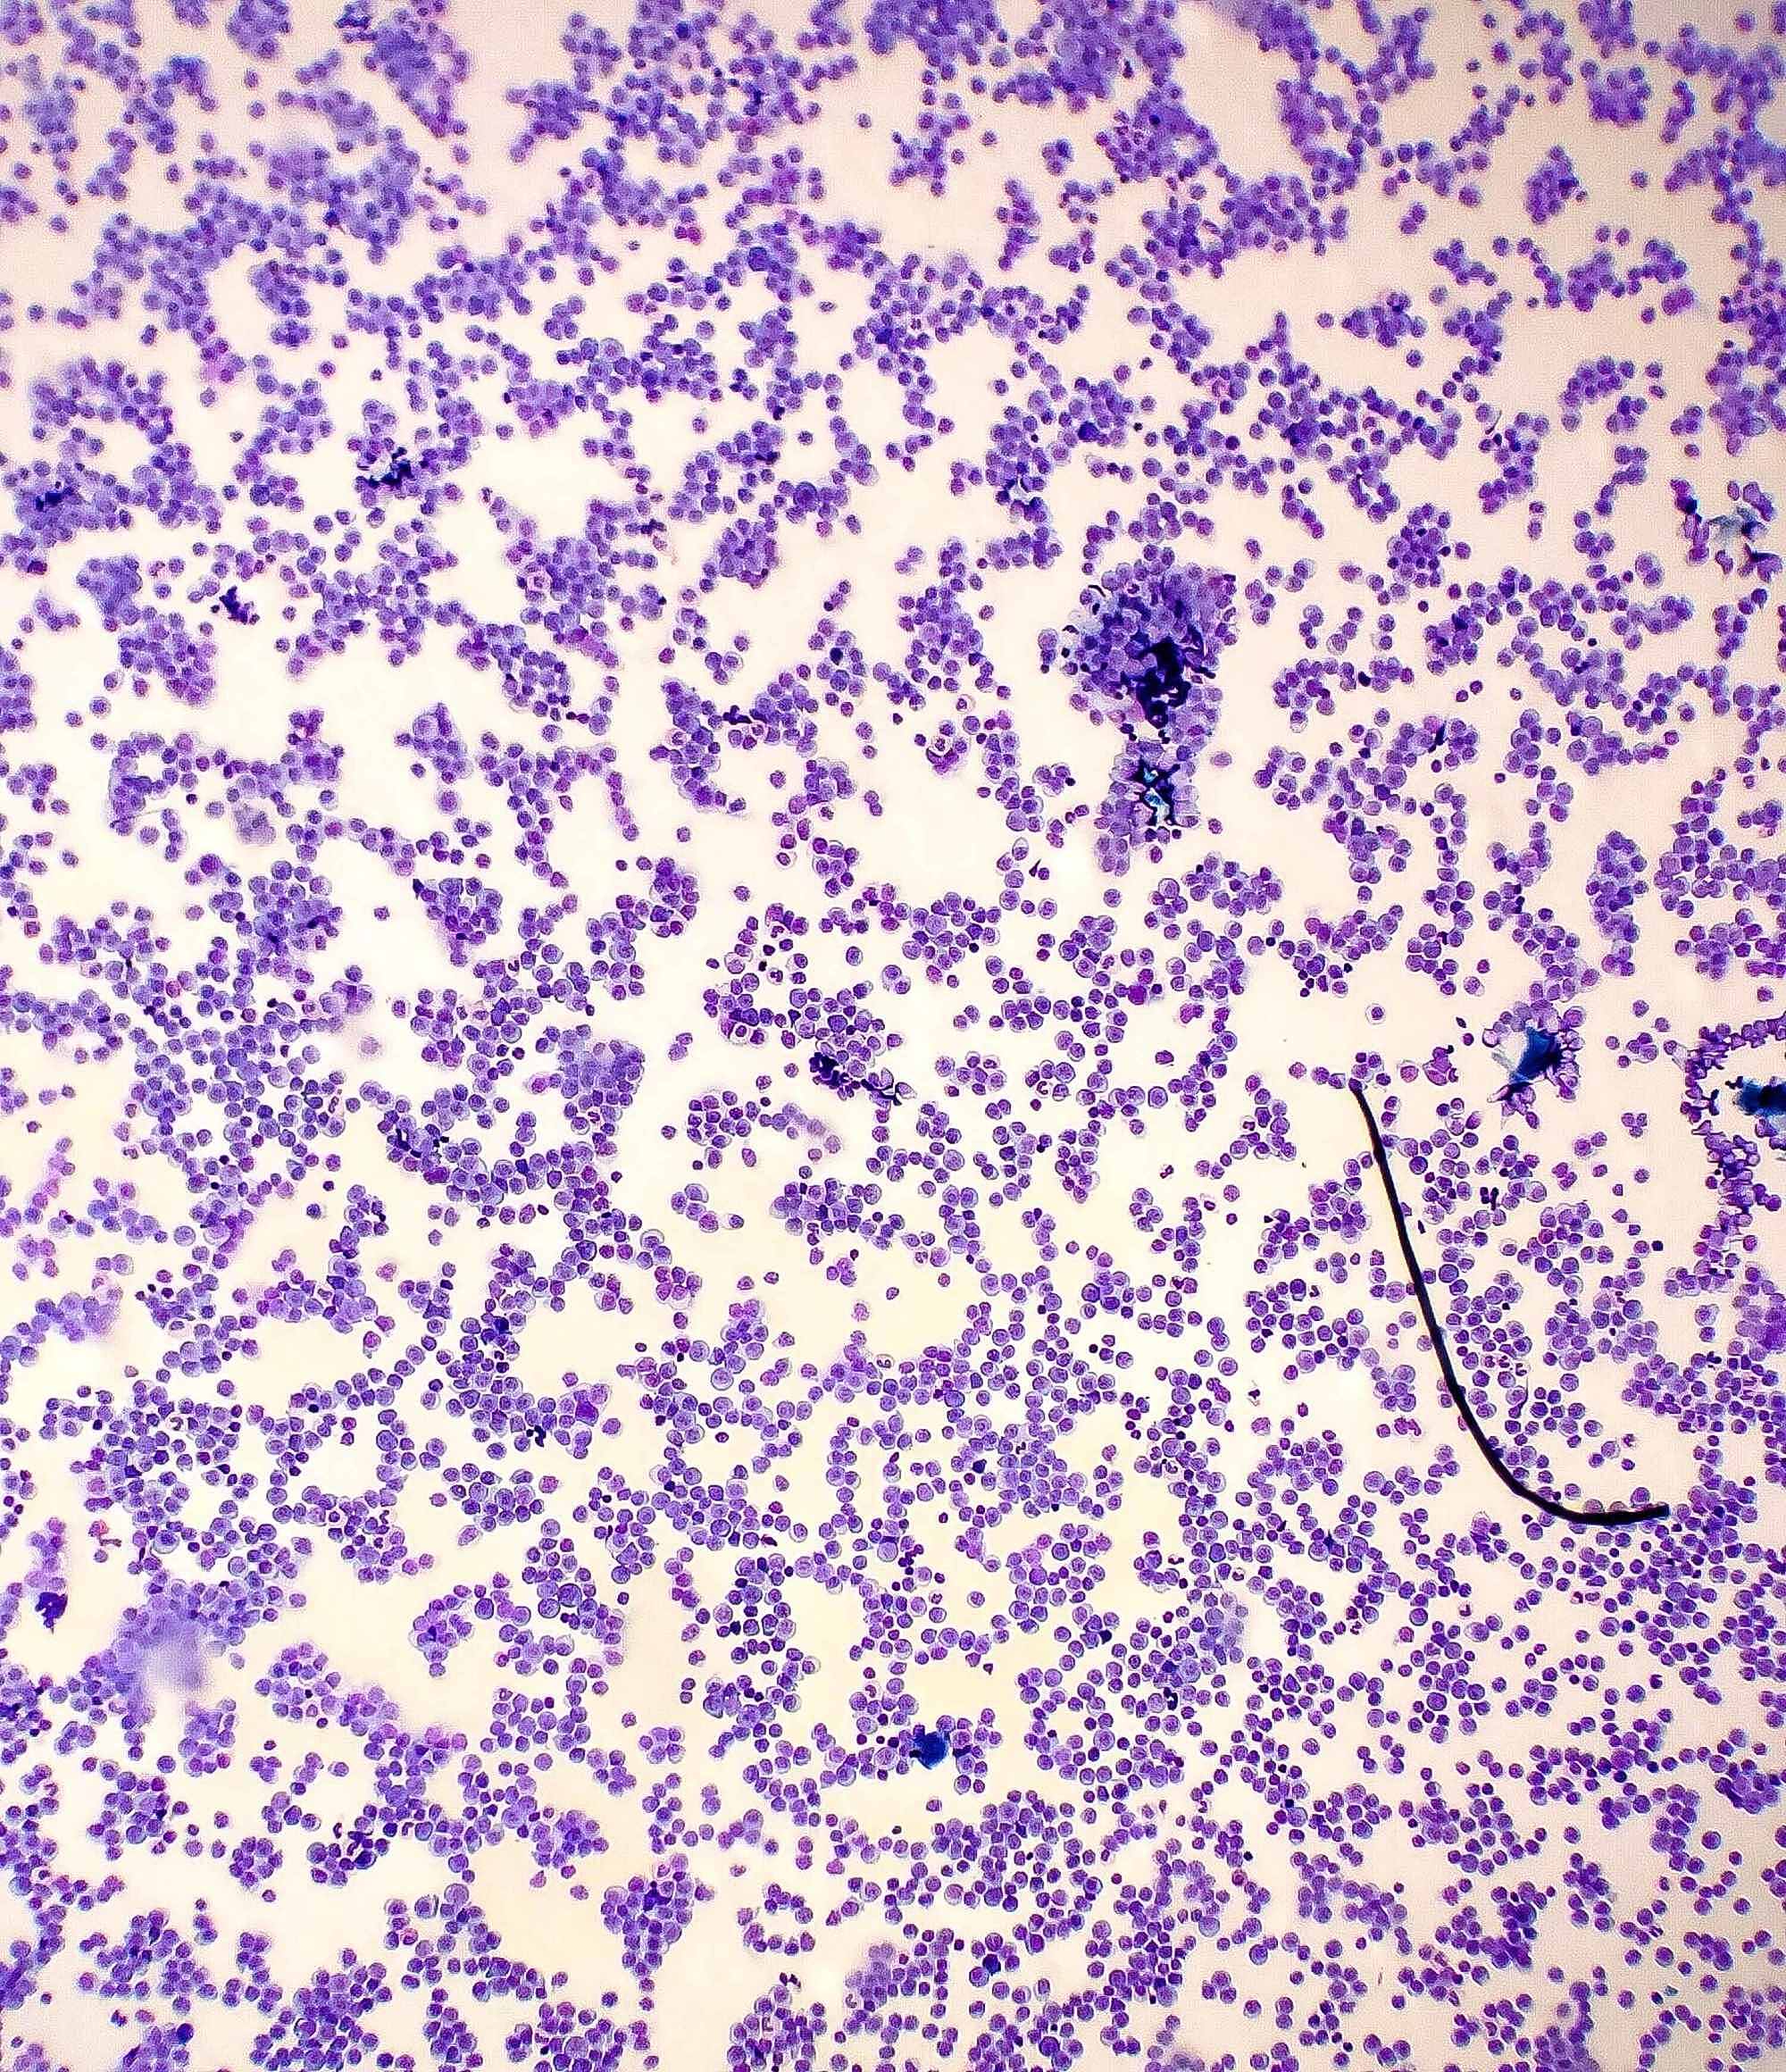
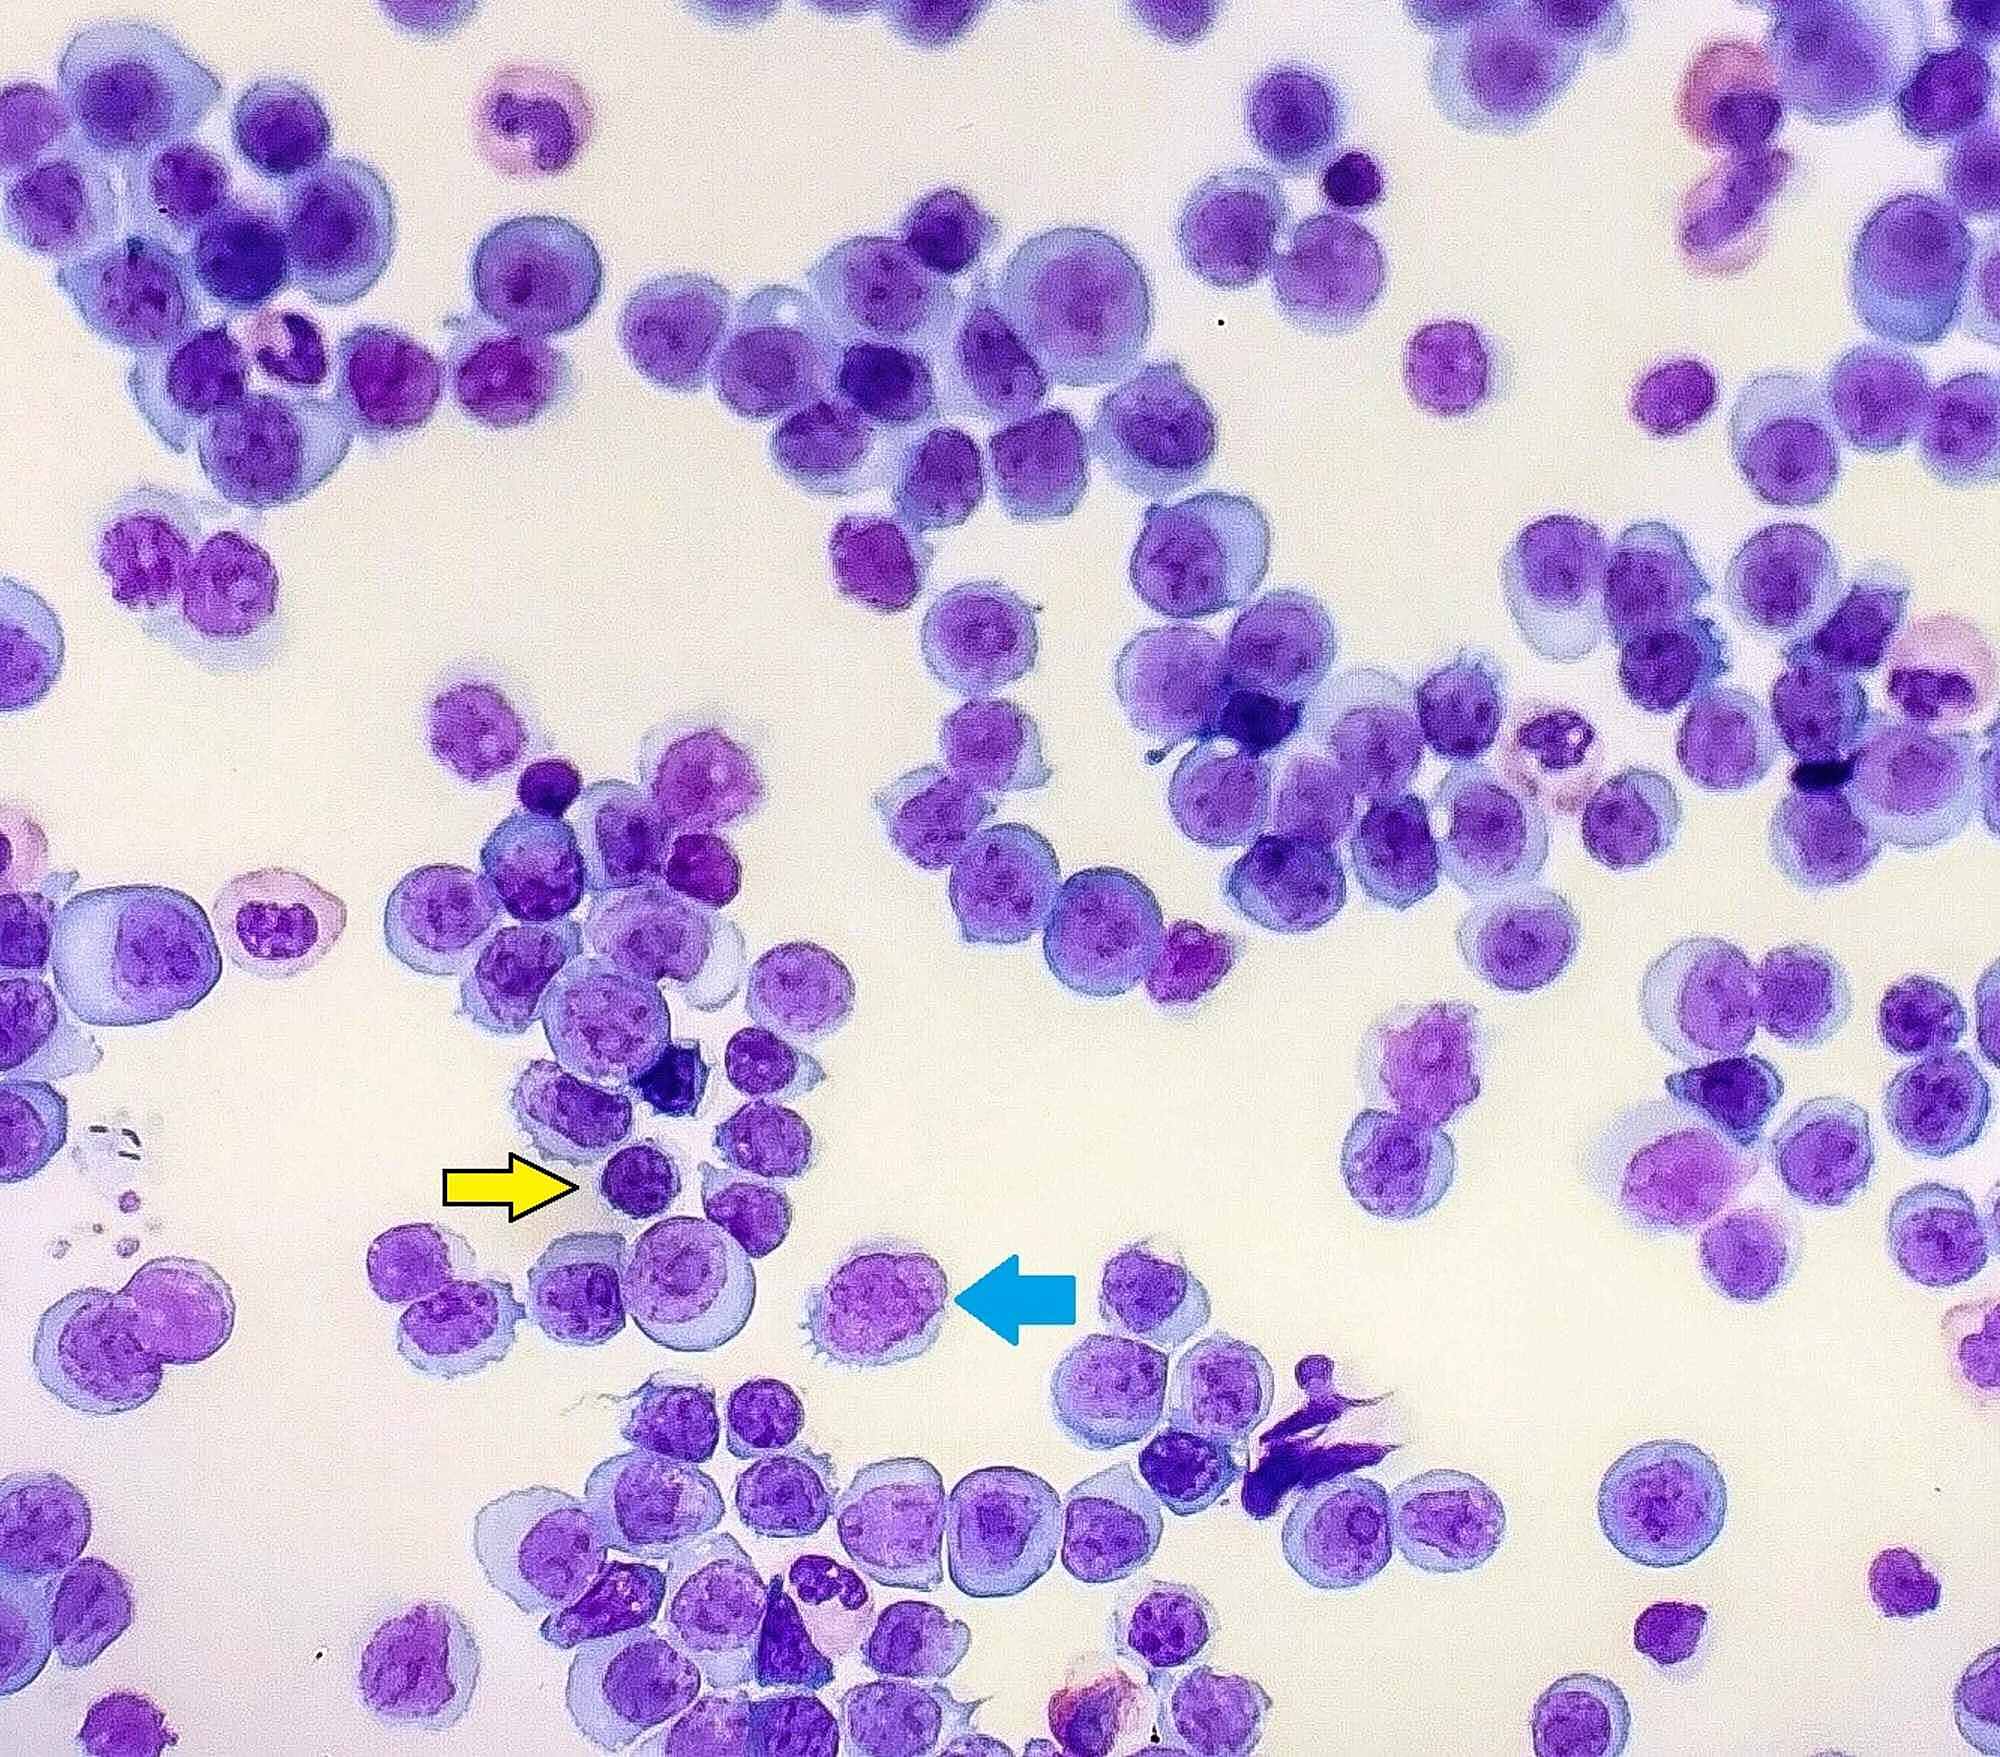

Syndrome De Richter
Richter syndrome (RS), also called Richter transformation, is now understood to describe the development of an aggressive lymphoma in patients with CLL or small lymphocytic lymphoma (SLL) The aggressive lymphoma in RS is most often of the diffuse large B cell type and less commonly appears as Hodgkin lymphoma.

Syndrome de richter. De Leval L, Vivario M, De Prijck B, et al Distinct clonal origin in two cases of Hodgkin’s lymphoma variant of Richter’s syndrome associated with EBV infection Am J Surg Pathol 04;–86. SUMMARY Richter transformation is defined as a diffuse large cell lymphoma, occurring by transformation of chronic lymphocytic leukemia (CLL) We present a 64yearold man with a history of CLL and a left parietooccipital transtentorial extraaxial mass The patient underwent CT and MR imaging, demonstrating a large duralbased mass with extracranial extension, which occluded the left. Richter's transformation, or Richter's syndrome, is an uncommon clinicopathological condition observed in about 5% to 10% of patients with chronic lymphocytic leukemia (CLL) This review summarizes advances in our understanding of the pathobiology and in the management of Richter's transformation in patients with CLL.
PubMed is a searchable database of medical literature and lists journal articles that discuss KotzotRichter syndrome Click on the link to view a sample search on this topic. Richter syndrome (RS) is defined as the transformation of chronic lymphocytic leukemia (CLL) into an aggressive lymphoma, most commonly diffuse large ell lymphoma (DLBCL) RS occurs in approximately 2% to 10% of CLL patients during the course of their disease, with a transformation rate of 05% to 1% per year. Richter’s Syndrome (RS), also known as Richter’s Transformation, is a rare complication of Chronic Lymphocytic Leukaemia (CLL) and/or Small Lymphocytic Lymphoma (SLL) It is characterised by the sudden transformation of the CLL/SLL into a significantly more aggressive form of large cell lymphoma Richter’s Syndrome occurs in approximately 210% of all CLL/SLL patients during the course of their disease.
A une r#{233}ticulopathie maligne, syndrome de Richter Nouv Rev Fr Hematol 462 1 , I 964 3 Trump DL, Mann RB, Phelps R, Roberts H, Conley CL Richter’s syndrome Diffuse histiocytic. Richter syndrome (RS) is defined as the transformation of chronic lymphocytic leukemia (CLL) into an aggressive lymphoma, most commonly diffuse large ell lymphoma (DLBCL) RS occurs in approximately 2% to 10% of CLL patients during the course of their disease, with a transformation rate of 05% to 1% per year. Richter syndrome describes the development of high‐grade non‐Hodgkin lymphoma (NHL) or Hodgkin lymphoma in patients with chronic lymphocytic leukemia (CLL)/small lymphocytic lymphoma (SLL) Richter transformation occurs in 3·3 to 10·6% of patients with CLL.
Dr Richter graduated from the Universidad De Cadiz Facultad De Medicina in 1981 He works in Plant City, FL and specializes in Internal Medicine Dr Richter is affiliated with South Florida Baptist Hospital. Richter's syndrome (RS) is a lifethreatening complication of chronic lymphocytic leukemia (CLL) Syndrome de Richter de type pseudohodgkinien À propos de deux cas et revue de la. Richter transformation is defined as the development of highgrade nonHodgkin lymphoma (NHL) in patients with chronic lymphocytic leukaemia (CLL) or small lymphocytic lymphoma (SLL) It has been expanded to include other lymphoid malignancies that develop in CLL patients, including Hodgkin disease, prolymphocytic leukaemia (TPLL), the Hodgkin variant of Richter transformation, small non.
Based on the available literature, mostly derived from retrospective or nonrandomized phase I or II studies, it is difficult to define an optimized treatment approach for patients developing Richter's syndrome (RS) Early recognition of chronic lymphocytic leukemia (CLL) patients presenting clinica. Richter’s transformation (RT) or syndrome is defined as the transition of CLL or small lymphocytic leukemia (SLL) into an aggressive lymphoma such as diffuse large ell lymphoma (DLBCL) or Hodgkin lymphoma (HL) RT is a rare complication of CLL, which occurs in approximately 210% of patients with CLL. Interrégionales d’Hématologie de l’Est Syndrome de Richter SNP et CNV par SNParrays Scandurra et al Hematol Oncol 10;.
In their review of patients with vermis hypoplasia, Kosaki et al (1997) identified a patient diagnosed as having Joubert syndrome () who had most findings of the RitscherSchinzel syndrome, and several other patients diagnosed as having DandyWalker syndrome (20) who likely also had RitscherSchinzel syndrome, suggesting that the. Guías de Información expand submenu for Guías de Información Preguntas Más Frecuentes Sobre Enfermedades Raras;. Maurice Richter, a pathologist from Bellevue Hospital in New York, initially described this transformation to a highgrade lymphoma in 1928 and, therefore, this condition is also referred to as Richter's transformation or Richter syndrome.
Amaigrissement (au moins 10 % du poids corporel en six mois) ;. Richter’s syndrome Richter's syndrome is a rare type of nonHodgkin lymphoma (NHL) NHL is a cancer of the lymphatic system People who develop Richter's syndrome have a type of blood cancer called chronic lymphocytic leukaemia (CLL) The leukaemia cells get into the lymph nodes and start growing there. 5 Syndrome de Richter L’évolution est caractérisée par la possibilité d’une transformation en lymphome B à grandes cellules (syndrome de Richter) Il doit être suspecté en cas de sueurs nocturnes ;.
Richter's syndrome (RS), also known as Richter's transformation, is a transformation of B cell chronic lymphocytic leukemia (CLL) or hairy cell leukemia into a fastgrowing diffuse large B cell lymphoma, a variety of nonHodgkin lymphoma which is refractory to treatment and carries a bad prognosis There is also a less common variant in which the CLL changes into a Hodgkin's lymphoma. 28 62–67 Hétérogénéité des profils, ce qui suggère différents soustypes de Richter, associés à différents mécanismes de transformation Implication de la voie MYC. Richter's transformation, or Richter's syndrome, is an uncommon clinicopathological condition observed in about 5% to 10% of patients with chronic lymphocytic leukemia (CLL) This review summarizes advances in our understanding of the pathobiology and in the management of Richter's transformation in patients with CLL.
Richter's transformation, or Richter's syndrome, is an uncommon clinicopathological condition observed in about 5% to 10% of patients with chronic lymphocytic leukemia (CLL) This review summarizes advances in our understanding of the pathobiology and in the management of Richter's transformation in patients with CLL. Richter transformation is defined as the development of highgrade nonHodgkin lymphoma (NHL) in patients with chronic lymphocytic leukemia (CLL) or small lymphocytic lymphoma (SLL) It has been expanded to include other lymphoid malignancies that develop in CLL patients, including Hodgkin disease, prolymphocytic leukemia (TPLL), the Hodgkin variant of Richter transformation, small non. This process is loosely termed “progression” and the words Richter’s transformation are not used in this setting Transformation A minority of patients (between 28%) develop diffuse large B cell lymphoma (DLBCL) These patients are said to have Richter’s transformation or Richter’s syndrome.
Richter syndrome (RS) is an uncommon evolution of chronic lymphocytic leukaemia (CLL) with a dismal prognosis Clinical‐biological features predicting outcome and best therapeutic approach for these patients remain to be established. Richter's Syndrome/Transformation is indeed a scary diagnosis, but we do have survivors in our community Promptly treating it provides the best outcome, but first you need proper diagnostic testing which must include a biopsy of the swollen node(s) to confirm the diagnosis and determine how/whether the transformation is clonally related to the primary cancer or denovo. Richter's syndrome (RS), also known as Richter's transformation, is a transformation of B cell chronic lymphocytic leukemia (CLL) or hairy cell leukemia into a fastgrowing diffuse large B cell lymphoma, a variety of nonHodgkin lymphoma which is refractory to treatment and carries a bad prognosis There is also a less common variant in which the CLL changes into a Hodgkin's lymphoma.
Richter’s Transformation (RT) or Richter’s Syndrome (RS) remains a major unmet need in CLL For a background on RT, please read this article by Dr Weistner from the National Institutes of Health (NIH) Briefly, RT occurs when the usually slow growing CLL/SLL transforms into a more aggressive lymphoma, usually diffuse large B cell lymphoma (DLBCL) and occasionally Hodgkin Lymphoma. The Richter scale – also called the Richter magnitude scale or Richter's magnitude scale – is a measure of the strength of earthquakes, developed by Charles F Richter and presented in his landmark 1935 paper, where he called it the "magnitude scale" This was later revised and renamed the local magnitude scale, denoted as ML or M L Because of various shortcomings of the M L scale, most. Síndrome de Richter é uma rara complicação da leucemia linfóide crônica (LLC) ou da tricoleucemia (HCL) Na síndrome de Richter, a LLC transformase em uma forma agressiva onde as células B crescem rapidamente Ela acomete cerca de 2% a 8% dos pacientes com LLC.
Joubert syndrome often manifests with similar cerebellar hypoplasia and its sequelae, including hyperpnea, ataxia, changes in eye movement, and cleft lip and palate Occasionally, Joubert syndrome will include heart malformations Brachmannde Lange syndrome must also be differentiated from 3C syndrome It presents with similar craniofacial and. Associated with cachexia, pyrexia, dysproteinemia, and lymphomas with multinucleated tumor cells. Augmentation des LDH ;.
A síndrome de Richter (RS), também conhecida como transformação de Richter, referese à transformação de um tipo específico de câncer no sangue em um tipo diferente e mais agressivo RS referese ao desenvolvimento de linfoma não Hodgkin de alto grau em uma pessoa que tem leucemia linfocítica crônica (LLC) / linfoma linfocítico. Richter’s syndrome (RS), also known as Richter’s transformation, refers to the transformation of one specific blood cancer type into a different, more aggressive type RS refers to the development of highgrade nonHodgkin lymphoma in a person who has chronic lymphocytic leukemia (CLL)/small lymphocytic lymphoma (SLL). Richter syndrome (RS) is the development of an aggressive lymphoma in patients with chronic lymphocytic leukemia (CLL) Two pathologic variants of RS are recognized namely, the diffuse large ell lymphoma (DLBCL) variant and the rare Hodgkin lymphoma (HL) variant Histologic documentation is mandatory to diagnose RS.
Richter syndrome ( rik'tĕr ), a highgrade lymphoma developing during the course of chronic lymphocytic leukemia;. The first study compared the genetic profiles of patients with CLL, the CLL phase prior to the development of Richter syndrome, Richter syndrome, and de novo DLBCL The study found TP53 inactivation, by either a mutation or a deletion, in the majority of patients at the time of transformation The researchers also found activation of CMYC and. Le syndrome de Richter est classiquement de mauvais pronostic, avec une mediane de survie de 6 mois 2, 4, et il n'y a pas de facteurs predictifs de survenue Les mecanismes pathogeniques sont mal connus mais une origine commune des cellules lymphomateuses et des cellules de leucemie lymphoide chronique a partir d'un clone unique est suggeree.
Associated with cachexia, pyrexia, dysproteinemia, and lymphomas with multinucleated tumor cells. Interrégionales d’Hématologie de l’Est Syndrome de Richter SNP et CNV par SNParrays Scandurra et al Hematol Oncol 10;. Dr David Richter, MD is a Rheumatology Specialist in Akron, OH and has over 47 years of experience in the medical field Dr Richter has more experience with Osteoporosis, Arthritis and Arthropathy, and Autoimmune Diseases than other specialists in his area He graduated from University Of Melbourne medical school in 1974 He is affiliated with medical facilities such as Akron General Medical.
Richter syndrome (RS) is the development of an aggressive lymphoma in patients with chronic lymphocytic leukemia (CLL) Two pathologic variants of RS are recognized namely, the diffuse large ell lymphoma (DLBCL) variant and the rare Hodgkin lymphoma (HL) variant Histologic documentation is mandatory to diagnose RS. In this study, participants with relapsed or refractory primary mediastinal large ell lymphoma (rrPMBCL) or relapsed or refractory Richter Syndrome (rrRS) will receive pembrolizumab (MK3475) The efficacy of pembrolizumab in the treatment of rrPMBCL and rrRS will be evaluated. Richter syndrome is a rare condition in which chronic lymphocytic leukemia (CLL) changes into a fastgrowing type of lymphoma Symptoms of Richter syndrome can include fever, loss of weight and muscle mass, abdominal pain, and enlargement of the lymph nodes , liver, and spleen.
28 62–67 Hétérogénéité des profils, ce qui suggère différents soustypes de Richter, associés à différents mécanismes de transformation Implication de la voie MYC. Richter syndrome ( rik'tĕr ), a highgrade lymphoma developing during the course of chronic lymphocytic leukemia;. Fièvre au long cours ;.
Children were relatively spared during COVID19 pandemic However, the recently reported hyperinflammatory syndrome with overlapping features of Kawasaki disease and toxic shock syndrome—“Paediatric Inflammatory Multisystem Syndrometemporally associated with SARSCoV2” (PIMSTS) has caused concern We describe cardiac findings and shortterm outcomes in children with PIMSTS at a. Cwynarski K, van Biezen A, de Wreede L, et al Autologous and allogeneic stemcell transplantation for transformed chronic lymphocytic leukemia (Richter’s syndrome) a retrospective analysis from the chronic lymphocytic leukemia Subcommittee of the chronic leukemia Working Party and lymphoma Working Party of the European Group for blood and. Richter’s syndrome Richter's syndrome is a rare type of nonHodgkin lymphoma (NHL) NHL is a cancer of the lymphatic system People who develop Richter's syndrome have a type of blood cancer called chronic lymphocytic leukaemia (CLL) The leukaemia cells get into the lymph nodes and start growing there.
Hypercalcemia has been described as arising during the course of Hodgkin's or non‐Hodgkin's lymphoma, 1 and adult T‐cell leukemia 1, 2 Its pathophysiology is attributed to the production of local and/or systemic factors, such as cytokines, calcitriol, or parathormone‐related peptide (PTHrP) 13 Richter's syndrome (RS) is defined as a high grade lymphoma occurring during the course of a. Sept 16, Back to school tips for parents supporting home learners. Richter's syndrome (RS) has been defined as “histiocytic” lymphoma (HL) or Hodgkin's disease (HD) supervening in the course of chronic lymphocytic leukemia (CLL) and related disorders The clinical, histologic, and immunologic findings in 25 cases (11 women, 14 men) of RS are presented.
Le syndrome de Richter est la survenue d'un lymphome de haut grade au cours d'une leucémie lymphoïde chroniqueIl s'observe dans 3 à 10 % des cas L'apparition d'un syndrome de Richter classe immédiatement la LLC en stade C de la classification de BinetIl a été décrit en 1928 par le pathologiste américain MN Richter. Treatment combining chemotherapy with immunotherapy as well as novel targeted therapies have shown limited efficacy in Richter syndrome Overall response rates after chemoimmunotherapy range from 43% to 67%, but remissions are generally shortlived In chronic lymphocytic leukemia (CLL), allogeneic hematopoietic cell transplantation (allHCT) is considered a potentially curative treatment. Richter syndrome (RS) is an aggressive lymphoma arising on the back of chronic lymphocytic leukemia (CLL)/small lymphocytic lymphoma (SLL) and is the most common ell malignancy in the Western world In the majority of cases, RS presents an activated B cell (ABC) phenotype of diffuse large ell lymphoma (DLBCL).
Blog Sept 17, Sales trends 10 ways to prepare for the future of sales;. De Leval L, Vivario M, De Prijck B, et al Distinct clonal origin in two cases of Hodgkin’s lymphoma variant of Richter’s syndrome associated with EBV infection Am J Surg Pathol 04;–86. Fraitag S, Bodemer C, Rousselot P, Hermine O, MacIntyre E, De Prost Y, Varet B, Brousse N Transformation cutanée d'une leucémie lymphoïde chronique en lymphome immunoblastique Présentation cutanée d'un syndrome de Richter Ann Dermatol Venereol 1995;.
Richter's syndrome (RS) is a lifethreatening complication of chronic lymphocytic leukemia (CLL) Syndrome de Richter de type pseudohodgkinien À propos de deux cas et revue de la. Approximately 10% of patients with chronic lymphocytic leukaemia (CLL) experience transformation to Richter syndrome (RS) 1 Associated with an aggressive disease course often refractory to chemotherapy, RS demonstrates poor outcomes, especially for patients with prior CLL treatment and even more so for patients with relapsed/refractory (RR) disease 24 Rituximab‐containing combination. Richter's syndrome (RS), also known as Richter's transformation, is a transformation of B cell chronic lymphocytic leukemia (CLL) or hairy cell leukemia into a fastgrowing diffuse large B cell lymphoma, a variety of nonHodgkin lymphoma which is refractory to treatment and carries a bad prognosis.
Le syndrome de Richter est classiquement de mauvais pronostic, avec une mediane de survie de 6 mois 2, 4, et il n'y a pas de facteurs predictifs de survenue Les mecanismes pathogeniques sont mal connus mais une origine commune des cellules lymphomateuses et des cellules de leucemie lymphoide chronique a partir d'un clone unique est suggeree. Richter's transformation when CLL transforms into a more aggressive lymphoma occurs in roughly 5% to 10% of patients with CLL According to past data, nearly all of these (95%) become DLBCL. A une r#{233}ticulopathie maligne, syndrome de Richter Nouv Rev Fr Hematol 462 1 , I 964 3 Trump DL, Mann RB, Phelps R, Roberts H, Conley CL Richter’s syndrome Diffuse histiocytic.
Richter syndrome (RS) is the development of an aggressive lymphoma in patients with chronic lymphocytic leukemia (CLL) Two pathologic variants of RS are recognized namely, the diffuse large ell lymphoma (DLBCL) variant and the rare Hodgkin lymphoma (HL) variant Histologic documentation is mand. Monoclonal antibodies (MABs) are a type of biological therapyThey are manmade proteins that target specific proteins on cancer cellsMABs are a fairly new treatment for cancer Doctors often use the MAB drug called rituximab along with chemotherapy and steroids to treat Richter syndromeResearchers in a trial called the CHOPOR study are studying whether a new biological therapy similar to.

My Cll Trail Richter S Syndrome My Luck May Just Be Running Out

Chronic Lymphocytic Leukemia Wikipedia

Cours Leucemies Lymphoides Chroniques
Syndrome De Richter のギャラリー
Collegebvh Org System Files Fichiers Document Fichiers H05 Trimoreau Leymarie Lymphocytoseb Pdf
Dlbcl Variant Of Richter Transformation In Cll
Collegebvh Org System Files Fichiers Document Fichiers H05 Trimoreau Leymarie Lymphocytoseb Pdf
Www Canceropole Est Org Sites Default Files Ihe Broseus Pdf

Richter Transformation Of Chronic Lymphocytic Leukemia Presenting As A Dural Based Non Hodgkin Lymphoma Mass American Journal Of Neuroradiology

Dependance Affective A Quel Degre Etes Vous Dependant Echelle De Richter Ma Chronique
2

Computed Tomography Textural Analysis For The Differentiation Of Chronic Lymphocytic Leukemia And Diffuse Large B Cell Lymphoma Of Richter Syndrome Springerlink

Hormonale Anticonceptie De Pil

Confrontations Abp

Leucemie Lymphoide Chronique Symptomes Evolution Et Traitements Web Libre

An Update For Richter Syndrome New Directions And Developments Eyre 17 British Journal Of Haematology Wiley Online Library

Cours Leucemies Lymphoides Chroniques

Biology And Treatment Of Richter Syndrome Sciencedirect

Pdf How We Treat Richter Syndrome

Anatomie Et Cytologie Pathologiques

Deletions At 11q23 In Different Lymphoma Subtypes

Calameo Llc Cours

Full Text Immunochemotherapy For Richter Syndrome Current Insights Itt

Prolymphocytic And Richter S Transformation In Peripheral Blood A Case Report And Review Of Literature Rana Journal Of Hematology

Syndrome De Richter

Cours Leucemies Lymphoides Chroniques

The Challenge Of Treating Richter Syndrome Download Scientific Diagram

Frontiers Neuronal Redox Imbalance In Rett Syndrome Affects Mitochondria As Well As Cytosol And Is Accompanied By Intensified Mitochondrial O2 Consumption And Ros Release Physiology

Diagnostic Et Prise En Charge Du Syndrome De Richter En 17 Louvain Medical
Http Www Sah Org Ar Revista Numeros 10 vol n3 16 Pdf

Confrontations Abp
Tumor Lysis Syndrome Caused By Unrecognized Richter S Transformation Of Chronic Lymphocytic Leukemia Treatment With Venetoclax For Suspected Disease Progression Cureus

Syndromes Lymphoproliferatifs Ppt Video Online Telecharger

Duodenal Stricture Secondary To Richter S Syndrome Revista De Gastroenterologia De Mexico

47 Leucemie Lymphoide Chronique Studocu
Dlbcl Variant Of Richter Transformation In Cll

Brugada Syndrome Management Aer Journal

Confrontations Abp

Eu Amo Hematologia Hematology Sindrome De Richter A Sindrome De Richter Sr Tambem Conhecida Como Transformacao De Richter E Uma Complicacao Rara Da Leucemia Linfocitica Cronica Llc E Ou Do
Www Amub Be Revue Medicale Bruxelles Download 9

Actualites Scientifiques Medicales Thelancethaematology Lymphomenonhodkinien Leucemielymphoidechronique Ibrutinib Nivolumab Securite Et Activite De L Ibrutinib En Combinaison Avec Le Nivolumab Chez Des Patients Atteints De Lymphome Non

Anatomie Et Cytologie Pathologiques
2

Histologic Transformation Of Chronic Lymphocytic Leukemia Small Lymphocytic Lymphoma Agbay 16 American Journal Of Hematology Wiley Online Library
Www Louvainmedical Be Sites Default Files Content Article Pdf Lmed 06 18 01 Vellemans Pdf
Www Canceropole Est Org Sites Default Files Ihe Broseus Pdf
Clinical Characteristics And Outcomes Of Richter Transformation Experience Of 4 Patients From A Single Center Haematologica
2

Leucemie Lymphoide Chronique
Cureus Tumor Lysis Syndrome Caused By Unrecognized Richter S Transformation Of Chronic Lymphocytic Leukemia Treatment With Venetoclax For Suspected Disease Progression
Syndrome De Richter De Type Pseudohodgkinien A Propos De Deux Cas Et Revue De La Litterature Em Consulte

Richter Syndrome Pathogenesis And Management Sciencedirect

Richter Syndrome
2

Brugada Syndrome Revista Espanola De Cardiologia English Edition

Confrontations Abp

Confrontations Abp

Eligibility For Pcsk 9 Inhibitors Treatment In Acute Coronary Syndrome Chronic Coronary Artery Disease And Outpatient Dyslipidemic Patients Atherosclerosis

Prolymphocytic And Richter S Transformation In Peripheral Blood A Case Report And Review Of Literature Rana Journal Of Hematology

Pdf How We Treat Richter Syndrome

Richter S Transformation Medsphere

Richter Transformation In Chronic Lymphocytic Leukemia Cll A Pooled Analysis Of German Cll Study Group Gcllsg Front Line Treatment Trials Leukemia

Bioinfo4women Covid 19 Doesn T Stop Our Internal Department Seminars We Had Presentations By Rominaroyo About Richter Syndrome Genomic Landscape While Lorenaalonso Ignasimoran Shared Their Work On Genomic Variation Impact

Richter Syndrome Pathogenesis And Management Sciencedirect

Richter S Transformation In The Era Of Targeted Therapy

Hodgkin S Lymphoma Transformation Of Cll Sll Case Report And Review Of The Literature

Eular Recommendations For The Management Of Sjogren S Syndrome With Topical And Systemic Therapies Annals Of The Rheumatic Diseases

Richter Syndrome Cll Cell Transformation Syndrome Hematology

Richter S Syndrome Disease Malacards Research Articles Drugs Genes Clinical Trials
Http Revues Ufhb Ci Org Fichiers Fichir Article 2115 Pdf
Hemato Chu Limoges Fr Hematolim Portals 0 Enseignement Dcem3 Lymphoide Llc Pdf

Novel Richter Syndrome Xenograft Models To Study Genetic Architecture Biology And Therapy Responses Cancer Research
Clinical Characteristics And Outcomes Of Richter Transformation Experience Of 4 Patients From A Single Center Haematologica

Factors Predicting Survival In Chronic Lymphocytic Leukemia Patients Developing Richter Syndrome Transformation Into Hodgkin Lymphoma Biosimilar Today
Syndrome De Richter Vulgaris Medical
Collegebvh Org System Files Fichiers Document Fichiers H05 Trimoreau Leymarie Lymphocytoseb Pdf
Q Tbn And9gcsvt170e2ujvmeas7xrbmflinhahxcpcgjuimzjzfaemqels33p Usqp Cau

The Stellar Trial Protocol A Prospective Multicentre Trial For Richter S Syndrome Consisting Of A Randomised Trial Investigation Chop R With Or Without Acalabrutinib For Newly Diagnosed Rs And A Single Arm Platform Study For
Q Tbn And9gcsko9dii3xhxcf3lvf3l0f Eovnlqsmz5gmhkavts Msojhguna Usqp Cau

Aspects Cytologiques Des Syndromes Lymphoproliferatif B Ppt Video Online Telecharger
Http Www Professionalabstracts Com Dgho19 Pdf Open Php Id 543 System List

Full Text Immunochemotherapy For Richter Syndrome Current Insights Itt
Collegebvh Org System Files Fichiers Document Fichiers H05 Trimoreau Leymarie Lymphocytoseb Pdf

Diagnostic Et Prise En Charge Du Syndrome De Richter En 17 Louvain Medical

Loop Sebastien Hergalant

The Heritability Of Pigment Dispersion Syndrome And Pigmentary Glaucoma American Journal Of Ophthalmology

Hodgkin S Lymphoma Transformation Of Cll Sll Case Report And Review Of The Literature

Confrontations Abp
Www Canceropole Est Org Sites Default Files Ihe Broseus Pdf
Www Canceropole Est Org Sites Default Files Ihe Broseus Pdf

Blood Journal Mir 125a And Mir 34a Expression Predicts Richter Syndrome In Chronic Lymphocytic Leukemia Patients T Co Rhgqjcizyx Cll T Co Bpyqapd10j

Irritable Bowel Syndrome Wikipedia

Association De Biologie Praticienne Pdf Free Download

6es Journees Du Filo Leucemies Aigues Myeloides Leucemie Lymphoide Chronique Waldenstrom Nancy 7 Au 9 Octobre

Diagnostic Et Pronostic De La Leucemie Lymphoide Chronique Llc

Manifestations Du Syndrome De Richter Dans La Cavite Buccale By France Beausejour On Prezi Next

Diagnostic Et Prise En Charge Du Syndrome De Richter En 17 Louvain Medical
/GettyImages-165564715-b233376a41de40668d8c50c5416d011f.jpg)
Richter S Syndrome Or Transformation Symptoms Causes Diagnosis And Treatment

Full Text Immunochemotherapy For Richter Syndrome Current Insights Itt

Sindrome Hemofagocitico Asociado A Sindrome De Richter Estudio De Un Caso Autopsico Y Revision De La Literatura
Dlbcl Variant Of Richter Transformation In Cll
Http Www Ijcem Com Files Ijcem Pdf

Mise A Jour Sur Le Syndrome De Richter Nouvelles Directions Et Developpements



